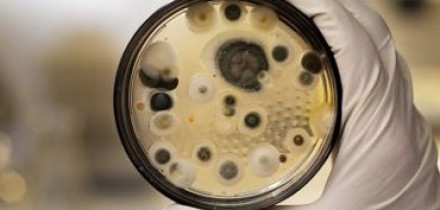

«محمد تقیزاده» شامگاه سهشنبه در گفت وگویی افزود: با توجه به افزایش میزان آلودگی هوا، مهدهای کودک، پیش دبستانی و مدارس ابتدایی سطح استان تهران در روز چهارشنبه (ششم آذرماه) در دو نوبت صبح و عصر تعطیل است.
به گفته وی، تصمیم تعطیلی مدارس ابتدایی استان تهران با توجه به افزایش شاخص آلایندگی هوا در سطح استان اتخاذ شده است.